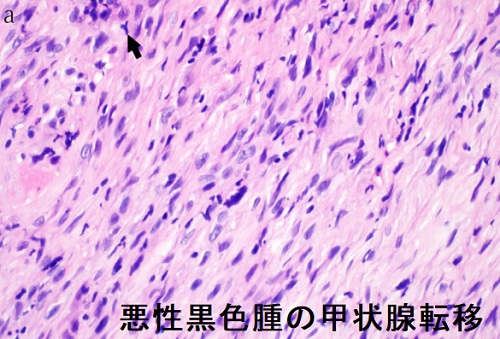
悪性黒色腫の甲状腺転移 組織像 悪性黒色腫の甲状腺転移 組織像
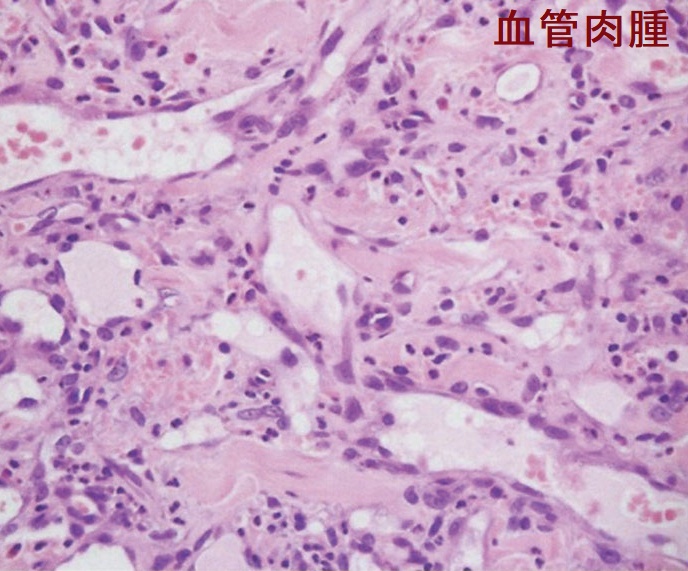
血管肉腫 病理組織H-E 染色標本 血管肉腫 病理組織H-E 染色標本

甲状腺と皮膚③良性・悪性腫瘍編,甲状腺癌の皮膚浸潤・皮膚転移, ボーエン病,パジェット病,メルケル細胞癌,基底細胞母斑症候群[長崎甲状腺クリニック]
甲状腺:専門の検査/治療/知見① 橋本病 バセドウ病 甲状腺エコー 長崎甲状腺クリニック大阪
長崎甲状腺クリニック(大阪)は甲状腺専門クリニックです。皮膚疾患の診療を行っておりません。
甲状腺専門の長崎甲状腺クリニック(大阪府大阪市東住吉区)院長が海外・国内論文に眼を通して得た知見、院長自身が大阪市立大学 附属病院 代謝内分泌内科で得た知識・経験・行った研究、甲状腺学会で入手した知見です。
長崎甲状腺クリニック(大阪)以外の写真・図表はPubMed等において学術目的で使用可能なもの(Creative Commons License)、public health目的で官公庁・非営利団体等が公表したものを一部改変しています。引用元に感謝いたします。尚、本ページは長崎甲状腺クリニック(大阪)の経費で非営利的に運営されており、広告収入は一切得ておりません。
甲状腺・動脈硬化・内分泌代謝に御用の方は 甲状腺編 動脈硬化編 内分泌代謝(副甲状腺/副腎/下垂体/妊娠・不妊等 をクリックください
Summary
甲状腺乳頭癌・甲状腺未分化癌の皮膚浸潤で発赤・変色・潰瘍形成。悪性黒色腫は甲状腺転移する。悪性黒色腫と甲状腺乳頭癌は共通のBRAF V600E突然変異を有し重複癌のリスク。外陰部パジェット病・乳房パジェット病(Paget病)の甲状腺転移は甲状腺超音波(エコー)検査で腫瘤無く橋本病(慢性甲状腺炎)様の不均質なびまん性腫大。メルケル細胞癌は神経内分泌腫瘍で悪性度高く、早期に甲状腺含む多臓器転移。根治切除不能メルケル細胞癌の治療薬、免疫チェックポイント阻害薬(抗PD-L1抗体)アベルマブ(バベンチオ®)は甲状腺機能障害、免疫関連有害事象(irAE)の副作用。
Keywords
皮膚転移,橋本病,甲状腺,甲状腺乳頭癌,悪性黒色腫,メルケル細胞癌,パジェット病,甲状腺未分化癌,ボーエン病,皮膚浸潤
甲状腺乳頭癌の皮膚浸潤・皮膚転移
甲状腺乳頭癌・甲状腺乳頭癌のリンパ節再発巣も頻度は少ないが皮膚浸潤、皮膚転移する場合があります。[Dermatologica. 1988;177(4):241-3.]
甲状腺の直上皮膚が変色、発赤、潰瘍形成などを起こします。当然、甲状腺癌もろとも合併切除。切除範囲が小さければ、直接縫合閉鎖で済みますが、広範囲切除なら、DP flap(deltopectoral flap;胸三角筋部皮弁)などを用いた形成外科手術が必要になります。
甲状腺乳頭癌が頭皮に転移した珍しい報告もあります。複数の赤みを帯びた結節を形成し、皮膚生検と免疫組織染色で確定。[Dermatologica. 1988;177(4):241-3.]
甲状腺乳頭癌または甲状腺濾胞癌の皮膚転移の大部分は頭頸部です[Thyroid. 1998 Nov;8(11):1045-50.]。
濾胞型甲状腺乳頭癌の皮膚転移[Actas Dermosifiliogr. 2016 Jan-Feb;107(1):86-8.]
局所再発進行甲状腺乳頭癌の皮膚浸潤に対する治療例
局所再発し、皮膚まで出て来た進行甲状腺乳頭癌は、表面から出血して貧血が進み、輸血を必要とする事があります。また、進行甲状腺乳頭癌の皮膚浸潤に「放射線治療無効な甲状腺癌」にネクサバール・レンビマ を用いた場合も、癌組織が崩壊すると出血します。
あまりに病勢コントロール不能な進行甲状腺乳頭癌において、腫瘍表面からの出血・貧血に対し、皮膚科的なMohs氏法と腫瘍栄養動脈塞栓術を組み合わせて治療した報告があります。(第53回 日本甲状腺学会 P-225 Mohs 氏法により治療した局所再発進行甲状腺乳頭癌の一例)
Mohs 氏法とは、末期がんの緩和ケアにおいて、局所の出血・感染をMohs ペーストで治療するものです(Arch Surg. 1941;42(2):279-295.)。Mohs ペーストは、 塩化亜鉛、亜鉛華でんぷん局方品、グリセリン局方品が主成分です。塩化亜鉛が腫瘍表面の水分でイオン化し、タンパク凝集作用により止血すると同時に殺菌効果も得られます。(Palliat Care Res 2009; 4(2): 346-350,)
甲状腺濾胞癌の皮膚浸潤、皮膚転移
甲状腺濾胞癌の皮膚転移も非常にまれで
- 男女比=3:1で男性に多い
- 広汎浸潤型濾胞癌、未分化転化を伴う濾胞癌、甲状腺濾胞癌(好酸性細胞型、Hürthle cell carcinoma)、島状成分を伴う濾胞癌など悪性度が高い
- 発症部位は甲状腺摘出術後の皮膚、頭皮、仙骨皮膚など様々
- 皮膚生検と免疫組織染色で確定。
[Am J Dermatopathol. 2005 Aug;27(4):306-12.]
甲状腺乳頭癌または甲状腺濾胞癌の皮膚転移の大部分は頭頸部です[Thyroid. 1998 Nov;8(11):1045-50.]。
母斑(色素性母斑:pigmented nevus:melanocytic nevus)はメラニン色素を作る良性の黒子(ホクロ)。円形で数mmから20cmを超える巨大色素性母斑まで様々。毛が1-2本生えている事もあります。表面は平坦でスムーズ、わずかな浸潤あり。内部に青白色・青灰色の境界不鮮明な領域あり。
巨大色素性母斑や、急激にサイズ増大するもの、左右非対称形のものは悪性化する可能性があります。
TRα(甲状腺ホルモン受容体アルファ)異常症では、皮膚細胞が過剰増殖状態にあり、主に頭部と頸部に皮膚いぼと母斑(色素性母斑)が生じます。これらの中には、癌化する危険のある遺伝子変異を有しているケースもあります。[Thyroid. 2021 Jul;31(7):1114-1126.]
黒色表皮腫(こくしょくひょうひしゅ:acanthosis nigricans)は、首・腋窩(脇の下)、臍窩(へそ)、鼠径部(脚の付け根)などが黒ずみ、硬く乳頭状(ざらざら)になった状態です。糖尿病・肥満におけるインスリン抵抗性・高インスリン血症による細胞増殖が原因。治療はインスリン抵抗性の解除。[Curr Pediatr Rev. 2022;19(1):68-82.]
黒色表皮腫は、糖尿病・肥満が関与する内分泌代謝疾患
- 先端巨大症(成長ホルモン産生下垂体神経内分泌腫瘍)
- クッシング症候群
- 甲状腺機能低下症;甲状腺ホルモン補充療法で改善[Pediatr Dermatol. 1986 Sep;3(4):323-6.]
- 多嚢胞性卵巣症候群(PCOS)
においても発生します[Dermatol Ther. 2020 Nov;33(6):e14521.]。
国立がんセンターの統計ではボーエン病(Bowen病)の癌化率は約5%、重複癌は約16%(乳癌, 悪性 リンパ腫, 胃癌, 子宮癌が多い)。多発性のボーエン病は約10%で、癌化率、重複癌 ともに25%です。
ボーエン病(Bowen病)に乳癌と甲状腺癌を合併したケースがあります。(Skin Cancer No. 3 267-272.)
有棘細胞がんは、「放射線治療無効な分化型甲状腺癌」に使用されるネクサバール®(ソラフェニブ)の副作用(手足症候群)の1つです[ネクサバール®(ソラフェニブ)の副作用]。
ネクサバール®(ソラフェニブ)の国際共同第Ⅲ相臨床試験(DECISION試験)で1.9%に認められました(Lancet. 2014 Jul 26;384(9940):319-28.)。
ネクサバール®(ソラフェニブ)によりBRAFのMAPキナーゼ経路が抑制されると、CRAFを介してMAPキナーゼ経路が強く活性化されるためと考えられます(Curr Opin Oncol. 2011 Mar;23(2):177-82.)(Clin Genitourin Cancer. 2009 Jan;7(1):20-3.)。
基底細胞母斑症候群[ゴーリン(Gorlin)症候群]
基底細胞母斑症候群[ゴーリン(Gorlin)症候群]に
- 甲状腺髄様癌を合併した(Head Neck. 2013 May;35(5):E147-52.)
- 甲状腺乳頭癌を合併した(Int J Surg Pathol. 2007 Jul;15(3):303-6.)
報告があります。
基底細胞癌
基底細胞癌は顔にできやすく、
- 中央部付近に赤褐色の血の付いたかさぶた(血痂)を伴う潰瘍があり、できては取れるを繰り返します。
- 樹枝状や蛇行状の長い血管(腫瘍血管)が見られる
- 病変の境界は不明瞭でイソギンチャクの様な形状(葉状、松葉様、線香花火様)です。
- 結節型は隆起する黒色小結節で、表面は平滑、青灰色の構造が特徴的
- 良性の黒子(ホクロ)と比べると、やや大きめで、形がいびつ、色合いがマダラです。
- 悪性黒色腫(メラノーマ)の甲状腺転移
- 悪性黒色腫(メラノーマ)と甲状腺乳頭癌の共通性(重複癌)
- 悪性黒色腫(メラノーマ)に投与する免疫チェックポイント阻害薬で甲状腺機能障害(免疫チェックポイント阻害薬による甲状腺機能障害(甲状腺irAE))
- 悪性黒色腫(メラノーマ)治療ニボルマブ(商品名:オプジーボ)で、無痛性甲状腺炎・甲状腺機能低下症
- 悪性黒色腫(メラノーマ)と非常によく似た爪甲下血腫
悪性黒色腫(メラノーマ)の甲状腺転移(転移性甲状腺癌(他臓器の癌から甲状腺への転移))
(Arch Endocrinol Metab. 2017 Mar-Apr;61(2):193-197.)(Ear Nose Throat J. 2009 Jan;88(1):E7.)
悪性黒色腫(メラノーマ)は顔よりも足の裏にできやすく、隆起はなく表面は平滑ですが、良性の黒子(ホクロ)と比べると、やや大きめで、形がいびつ、色合いがマダラです。
悪性黒色腫(メラノーマ)は濃淡のある褐色斑で、粗大で不規則な菱形構造の偽ネットワークを形成します。
悪性黒色腫(メラノーマ)は顔よりも足の裏にできやすく、隆起はなく表面は平滑ですが、良性の黒子(ホクロ)と比べると、やや大きめで、形がいびつ、色合いがマダラです。
悪性黒色腫(メラノーマ)は濃淡のある褐色斑で、粗大で不規則な菱形構造の偽ネットワークを形成します。
悪性黒色腫(メラノーマ)と甲状腺乳頭癌の共通性;共通のBRAF V600E突然変異を有し、重複癌を発症するリスクが高い(Hum Pathol. 2013 Nov;44(11):2563-70.)
母斑の数、毎日の紫外線露光量は甲状腺癌、甲状腺結節、甲状腺腫のリスクファクターとされます(Epidemiology. 2017 Sep;28(5):694-702.)。一方で、紫外線暴露により甲状腺癌のリスクが下がるとの報告もあります(Cancer Epidemiol Biomarkers Prev. 2017 May;26(5):684-691.)。
写真は、悪性黒色腫(メラノーマ)と甲状腺乳頭癌の重複癌(Ann Dermatol. 2010 Aug;22(3):370-2.)
パジェット病(Paget病)とは
パジェット病(Paget病)は、主に汗を産生する細胞が癌化し、表皮内から真皮に浸潤したもので、60歳以上の高齢者に多いです。
- 乳頭・乳輪に生じる乳房パジェット病
- 陰部・腋・肛門周囲などに生じる乳房外パジェット病
があります。
外陰部パジェット病(Paget病)の症例
最初は扁平上皮癌を疑われ、摘出後、外陰部パジェット病(Paget病)と診断された報告例があります。術後5年して、PET-CTで甲状腺にびまん性集積を認めるも、甲状腺超音波(エコー)検査で特に腫瘤は無く、橋本病(慢性甲状腺炎)を疑わせる不均質なびまん性腫大。術後4年間のPET-CTで甲状腺に異常はなかったため、外陰部パジェット病(Paget病)の甲状腺転移を疑い、穿刺吸引細胞診でPaget細胞を確認したそうです。(第60回 日本甲状腺学会 P1-9-8 甲状腺転移を来した外陰部Paget病の1例)
外陰部パジェット病(Paget病)と甲状腺乳頭癌の合併報告もあります。[The Journal of Medical Research 2023; 9(2):16-19]
乳房パジェット病(Paget病)
乳癌の甲状腺転移の約半数は、びまん浸潤型で橋本病(慢性甲状腺炎)と誤診される危険性があります(Cancer 15: 557-565, 1962)。(橋本病の甲状腺内に広範な、びまん性砂粒状石灰化)
メルケル細胞は表皮と真皮の境界に存在し、触覚を司る神経内分泌細胞です。
近年増加傾向にあるメルケル細胞癌は高齢者に多く、日光に当たると増殖する神経内分泌腫瘍です。メルケル細胞ポリオーマウイルスが関与し、悪性黒色腫より悪性度が高く、早期にリンパ節、肺、脳、骨、甲状腺にも転移します。(Diagn Cytopathol. 2010 Oct;38(10):754-7.)神経内分泌腫瘍なのでオクトレオチドスキャン(ソマトスタチン受容体シンチグラフィ、SRS、オクトレオスキャン®)で転移部位を検索。
根治切除不能なメルケル細胞癌の治療薬、免疫チェックポイント阻害薬(抗PD-L1抗体)アベルマブ(バベンチオ®)は
の副作用があります。
血管肉腫は
- 高齢者の頭部・顔面に外傷を契機として発症(打撲後のあざが治らない)
- 副腎、甲状腺、皮膚、骨など、さまざまな原発部位に発生(稀中の稀、誰も知らない甲状腺血管肉腫)[Arch Pathol Lab Med. 2011 Feb;135(2):268-72.]
- 不明瞭な紫紅色斑が急激に増大、隆起、出血、潰瘍・結節形成
- リンパ節転移、遠隔転移(特に肺転移)
- 病理組織所見は、①紡錘形異型細胞(軽度から中等度の多形性類上皮細胞)と②赤血球を含んだ大小の管腔形成[Arch Pathol Lab Med. 2011 Feb;135(2):268-72.]
甲状腺関連の上記以外の検査・治療 長崎甲状腺クリニック(大阪)
- 甲状腺編
- 甲状腺編 part2
- 内分泌代謝(副甲状腺/副腎/下垂体/妊娠・不妊等
も御覧ください
長崎甲状腺クリニック(大阪)とは
長崎甲状腺クリニック(大阪)は日本甲状腺学会認定 甲状腺専門医[橋本病,バセドウ病,甲状腺超音波(エコー)検査など]による甲状腺専門クリニック。大阪府大阪市東住吉区にあります。平野区,住吉区,阿倍野区,住之江区,松原市,堺市,羽曳野市,八尾市,生野区,東大阪市,天王寺区,浪速区も近く。